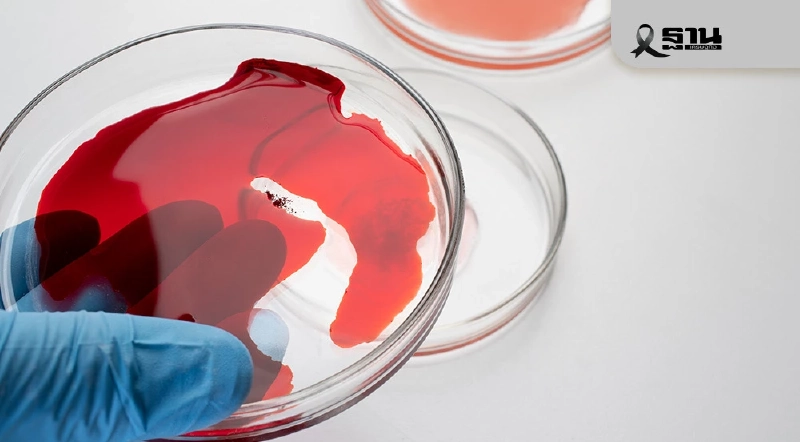

พลิกโฉมการวางผังเมือง รองรับการเปลี่ยนแปลงสภาพภูมิอากาศ เพื่อความยั่งยืน

- กรมโยธาธิการและผังเมืองจัดสัมมนาวิชาการในหัวข้อ “ธรรมชาติในเมือง” เพื่อเป็นเวทีขับเคลื่อนการวางผังเมืองที่ยั่งยืนและรองรับการเปลี่ยนแปลงสภาพภูมิอากาศ
- การสัมมนารวบรวมผู้เชี่ยวชาญจากภาครัฐ ภาคเอกชน และองค์กรระหว่างประเทศ เพื่อแลกเปลี่ยนแนวคิดและประสบการณ์ในการออกแบบเมืองให้พร้อมรับมือวิกฤตภูมิอากาศ
- มีการนำเสนอแนวทางและนวัตกรรมสำคัญในการพัฒนาเมือง เช่น การใช้ธรรมชาติเป็นพื้นฐาน (Nature-Based Solution) เมืองซับน้ำ (Sponge City) และมาตรฐานอาคารเขียว (Green Building)
- มุ่งเน้นการสร้างความตระหนักรู้และส่งเสริมการมีส่วนร่วมจากทุกภาคส่วน โดยจัดงานพร้อมกันทั่วประเทศใน 76 จังหวัด เพื่อให้การพัฒนาผังเมืองบรรลุผลสำเร็จ
กระทรวงมหาดไทย โดยกรมโยธาธิการและผังเมือง จัดสัมมนาทางวิชาการเนื่องในวันผังเมืองโลก 2568 เรื่อง “City in Nature for Climate change ธรรมชาติในเมือง เพื่อรองรับการเปลี่ยนแปลงสภาพภูมิอากาศ” ดึงผู้เชี่ยวชาญ ทั้งภาครัฐ ภาคเอกชน มาร่วมแชร์ประสบการณ์ แลกเปลี่ยนแนวคิด เป็นเวทีการขับเคลื่อนการวางผังเมือง และออกแบบเมืองเพื่อความยั่งยืน ภายใต้แนวคิดและทิศทางการพัฒนาประเทศกับการเปลี่ยนแปลงของสภาพภูมิอากาศ การพัฒนาเมืองและการดำรงชีวิตให้สอดคล้องกับการเปลี่ยนแปลงสภาพภูมิอากาศเมื่อไม่นานมานี้
รวมทั้งการบรรเทาผลกระทบจากการเปลี่ยนแปลงของสภาพภูมิอากาศ โดยการเผยแพร่ความรู้ความเข้าใจต่อสาธารณชนเกี่ยวกับแนวคิดนวัตกรรมและแนวทางการนำผังเมืองไปสู่การปฏิบัติ ส่งเสริมและสนับสนุนให้ทุกภาคส่วนตระหนักรู้ มีจิตสำนึกรับผิดชอบ มีส่วนร่วมตามบทบาทหน้าที่ที่เหมาะสม และเป็นกลไกขับเคลื่อนให้การพัฒนาด้านการผังเมืองของประเทศไทยบรรลุผลสำเร็จ
โดยมี นายศักดิ์ดา วิเชียรศิลป์ รัฐมนตรีช่วยว่าการกระทรวงมหาดไทย เป็นประธานเปิดงาน นายพงษ์นรา เย็นยิ่ง อธิบดีกรมโยธาธิการและผังเมือง กล่าวรายงาน พร้อมด้วย His Excellency Datuk Wan Zaidi Wan Abdullah Ambassador EMBASSY OF MALAYSIA เอกอัครราชทูตมาเลเซียประจำประเทศไทย นายจุมพฏ วรรณฉัตรสิริ รองปลัดกระทรวงมหาดไทย นายอุกกฤต สตภูมินทร์ รองอธิบดีกรมทรัพยากรทางทะเลและชายฝั่ง นายชาญวิชญ์ สิริสุนทรานนท์ สถาปนิกใหญ่ กรมโยธาธิการและผังเมือง Ms. Jing Yu, Ph. D. Deputy Chief, UN-Habitat Bangkok Multi-Country Programme Office นายอิทธิพงศ์ ตันมณี หัวหน้าผู้ตรวจราชการกรมโยธาธิการและผังเมือง ผู้บริหาร ผู้อำนวยการสำนัก/กอง เจ้าหน้าที่และหน่วยงานที่เกี่ยวข้อง ร่วมการสัมมนา ณ ห้องแกรนด์บอลรูม โรงแรมโกลเด้น ทิวลิป ซอฟเฟอริน กรุงเทพมหานคร
ทั้งนี้ ตามนโยบายของ นายอนุทิน ชาญวีรกูล รองนายกรัฐมนตรีและรัฐมนตรีว่าการกระทรวงมหาดไทย ที่มุ่งเน้นให้กรมโยธาธิการและผังเมือง ขับเคลื่อนนโยบายผังเมืองสู่ประชาชน เร่งประชาสัมพันธ์และเสริมสร้างความรู้ความเข้าใจเรื่องผังเมืองแก่ประชาชน เพื่อส่งเสริมการมีส่วนร่วมอย่างแท้จริง ในปีนี้ กรมโยธาธิการและผังเมือง โดยสำนักงานโยธาธิการและผังเมืองจังหวัด ทั้ง 76 จังหวัด
ได้ร่วมผนึกกำลังจัดงานสัมมนาขึ้นในแต่ละพื้นที่จังหวัดอย่างพร้อมเพรียงกันครอบคลุมทั่วทั้งประเทศ โดยในพิธีเปิดผู้ว่าราชการจังหวัดหรือผู้แทนผู้ว่าราชการจังหวัด ทั้ง 76 จังหวัด ได้ให้เกียรติเข้าร่วมพิธีเปิดผ่านระบบออนไลน์ด้วยโปรแกรม Cisco Webex Meetings และมีผู้เข้าร่วมการสัมมนาผ่านช่องทาง Facebook กรมโยธาธิการและผังเมือง PR และ YouTube กรมโยธาธิการและผังเมือง Official พร้อมกันทั้งในประเทศและต่างประเทศ
นายศักดิ์ดา วิเชียรศิลป์ รัฐมนตรีช่วยว่าการกระทรวงมหาดไทย กล่าวว่า ทุกวันนี้ทั่วโลกกำลังเผชิญกับความท้าทายที่ยิ่งใหญ่ ก็คือวิกฤตสภาพภูมิอากาศ ปัจจุบันเราจะเห็นพายุที่รุนแรงมากขึ้น คลื่นความร้อนที่ยาวนานและรุนแรงกว่าที่เคย น้ำท่วมฉับพลันและขยายวงกว้างมากยิ่งขึ้น ไฟป่า ภัยแล้ง
ที่ส่งผลกระทบต่อชีวิตของประชาชน ความมั่นคงทางอาหาร และเศรษฐกิจทั่วโลก สิ่งเหล่านี้ไม่ใช่เหตุการณ์ธรรมชาติที่เกิดขึ้นโดยบังเอิญ แต่เป็นผลลัพธ์จากการกระทำของมนุษย์ที่ทำลายสมดุลของธรรมชาติ โดยเฉพาะการปล่อยก๊าซเรือนกระจกอย่างมหาศาลจากภาคอุตสาหกรรม การขนส่ง และการใช้พลังงานจากฟอสซิล วิกฤตนี้ไม่เลือกสถานะ เชื้อชาติ หรือพรมแดน ทุกคนล้วนได้รับผลกระทบ ซึ่งอาจไม่เท่าเทียมกัน กลุ่มที่เปราะบางที่สุดมักต้องเผชิญกับผลกระทบที่รุนแรงที่สุด
ทั้งที่มีส่วนก่อปัญหาน้อยที่สุด ถึงเวลาแล้วที่เราจะไม่เพียงแค่ “พูดถึง” การเปลี่ยนแปลงสภาพภูมิอากาศ แต่ต้องลงมือทำอย่างจริงจังและเร่งด่วน โดยเริ่มต้นการสร้างธรรมชาติในเมืองเพื่อรองรับการเปลี่ยนแปลงสภาพภูมิอากาศร่วมกัน
กระทรวงมหาดไทย โดยกรมโยธาธิการและผังเมืองได้จัดงานสัมมนาฯ ขึ้นในครั้งนี้ถือเป็นโอกาสอันดีที่จะทำให้ท่านผู้มีเกียรติจากทุกภาคส่วนได้ใช้เป็นเวทีแลกเปลี่ยน และรับฟังความคิดเห็นจากหน่วยงาน องค์กรที่เกี่ยวข้องหลายภาคส่วน ทั้งภาครัฐ ภาคเอกชน ในการออกแบบสร้างธรรมชาติในเมือง การสร้างสรรค์เมือง และการขับเคลื่อนงานด้านการผังเมืองอย่างเป็นรูปธรรม ให้เมืองมีความพร้อมในทุกมิติ เพื่อรองรับวิกฤตภูมิอากาศที่ทุกวันจะทวีความรุนแรงมากยิ่งขึ้น
นายพงษ์นรา เย็นยิ่ง อธิบดีกรมโยธาธิการและผังเมือง กล่าวว่า กรมโยธาธิการและผังเมือง ดำเนินการจัดสัมมนาทางวิชาการเนื่องในวันผังเมืองโลกอย่างต่อเนื่องเป็นประจำทุกปี เพื่อเป็นเวทีการขับเคลื่อนงานด้านการผังเมือง และเปิดมุมมองใหม่ ๆ ซึ่งเป็นรากฐานของการพัฒนาเมืองไปสู่ความยั่งยืนในอนาคต โดยการเผยแพร่ความรู้ ความเข้าใจต่อสาธารณชนเกี่ยวกับแนวคิดนวัตกรรมและแนวทางการนำผังเมืองไปสู่การปฏิบัติ อีกทั้งส่งเสริมและสนับสนุนให้ทุกภาคส่วนตระหนักรู้ มีจิตสำนึกรับผิดชอบ มีส่วนร่วมตามบทบาทหน้าที่ที่เหมาะสม และเป็นกลไกขับเคลื่อนให้การพัฒนาด้านการผังเมืองของประเทศไทยบรรลุผลสำเร็จ
สำหรับการจัดงานในวันนี้กำหนดจัดขึ้นในหัวข้อ City in Nature for Climate change ธรรมชาติในเมือง เพื่อรองรับการเปลี่ยนแปลงสภาพภูมิอากาศ มีวัตถุประสงค์เพื่อเป็นเวทีแลกเปลี่ยนและรับฟังความคิดเห็นของผู้เชี่ยวชาญจากภาคส่วนต่าง ๆ ทั้งภาครัฐและภาคเอกชนมาร่วมเสนอแนวคิดและเปิดมุมมองใหม่ ๆ ดังนี้
1. การบรรยาย เรื่อง How to : อยู่กับธรรมชาติ Nature Based Solution : การใช้ธรรมชาติเพื่อพัฒนาเมือง โดย รศ.ดร.เสรี ศุภราทิตย์
2. การบรรยาย เรื่อง แนวทางในการพัฒนาเมืองซับน้ำ (Sponge City Development Guidelines) โดย รศ.ดร.สุธี อนันต์สุขสมศรี
3. การบรรยาย เรื่อง Start from Home : เริ่มต้นจากที่บ้าน โดย รศ.เฉลิมวัฒน์ ตันตสวัสดิ์
4. การบรรยาย เรื่อง Green Building Standards : มาตรฐานของอาคาร โดย ศ.ดร.อรรจน์ เศรษฐบุตร
หลังจากนั้นช่วงบ่ายมีเวทีการเสวนา เรื่อง “ธรรมชาติในเมือง เพื่อรองรับการเปลี่ยนแปลงสภาพภูมิอากาศ” โดยมี รศ.ดร.เสรี ศุภราทิตย์ ผู้อำนวยการศูนย์การเปลี่ยนแปลงภูมิอากาศและภัยพิบัติ มหาวิทยาลัยรังสิต คุณวรนุช สวยค้าข้าว รองผู้อำนวยการสำนักสิ่งแวดล้อม กรุงเทพมหานคร คุณธีรพงษ์ เหล่าพงศ์พิชญ์ ผู้แทนกรมการเปลี่ยนแปลงสภาพภูมิอากาศและสิ่งแวดล้อม และคุณวิลาสินี ภูนุชอภัย รองผู้อำนวยการโครงการ Urban-Act องค์กรความร่วมมือระหว่างประเทศของเยอรมัน (GIZ) มาร่วมแชร์ประสบการณ์ แลกเปลี่ยนแนวคิด
เพื่อเป็นเวทีแลกเปลี่ยนและรับฟังความคิดเห็นในการวางแผนและออกแบบเมือง พร้อมขับเคลื่อนงานด้านการผังเมือง สนองตอบต่อการแก้ไขปัญหาเพื่อรองรับการเปลี่ยนแปลงสภาพภูมิอากาศ วิธีการปรับตัวภายใต้สถานการณ์ปัจจุบัน รวมทั้งสร้างภูมิคุ้มกันเพื่อลดความเสี่ยงจากภัยพิบัติ และสามารถบรรลุเป้าหมายของการพัฒนาประเทศได้
กรมโยธาธิการและผังเมืองหวังว่า จะได้รับความรู้และมีความเข้าใจงานด้านการผังเมือง และการพัฒนาเมืองมากยิ่งขึ้น จากกิจกรรมต่าง ๆ ในงานที่อัดแน่นด้วยนักวิชาการที่มาร่วมเปิดมุมมองใหม่ ๆ ในการออกแบบเมืองให้มีความพร้อมในทุกมิติ สำหรับเมืองเพื่อการรองรับวิกฤตภูมิอากาศและปรับตัวได้ในสถานการณ์ของโลกที่เปลี่ยนแปลงไป ประชาชนดำเนินชีวิตอย่างมีความสุข พร้อมก้าวสู่การพัฒนาเมืองที่ยั่งยืนอย่างแท้จริง
ขอบคุณข้อมูลจาก thansettakij.com
การเคหะฯ ขับเคลื่อนโครงการสินเชื่อพัฒนาที่อยู่อาศัย สร้างโอกาสประชาชนมีบ้านเป็นของตนเอง

- การเคหะแห่งชาติ (กคช.) ขับเคลื่อนโครงการสินเชื่อเพื่อการพัฒนาที่อยู่อาศัย เพื่อช่วยเหลือผู้มีรายได้น้อยและกลุ่มเปราะบางให้มีบ้านเป็นของตนเอง
- ผลการดำเนินงานตั้งแต่ปี 2563–2568 ได้อนุมัติสินเชื่อไปแล้วกว่า 2,300 ล้านบาท ครอบคลุมประชาชนกว่า 3,600 ครัวเรือน
- โครงการนี้เป็นส่วนหนึ่งของนโยบาย “พม. ใกล้คุณ” ของกระทรวงการพัฒนาสังคมฯ ที่มุ่งสร้างความมั่นคงด้านที่อยู่อาศัยและยกระดับคุณภาพชีวิตประชาชน
การเคหะแห่งชาติ เดินหน้าขับเคลื่อนภารกิจตามนโยบายนายอัครา พรหมเผ่า รมว.พม. “พม. ใกล้คุณ” โครงการสินเชื่อเพื่อการพัฒนาที่อยู่อาศัยสำหรับผู้มีรายได้น้อย เพื่อให้ประชาชนทุกกลุ่ม โดยเฉพาะผู้มีรายได้น้อยและกลุ่มเปราะบาง เข้าถึงโอกาสในการมีที่อยู่อาศัยเป็นของตนเองอย่างมั่นคง พร้อมเผยผลการดำเนินงานตั้งแต่ปี 2563–2568 ปล่อยสินเชื่อรวมกว่า 2,300 ล้านบาท ครอบคลุมประชาชนกว่า 3,600 ครัวเรือนทั่วประเทศ
นายทวีพงษ์ วิชัยดิษฐ ผู้ว่าการการเคหะแห่งชาติ เปิดเผยว่า การเคหะแห่งชาติได้ดำเนินโครงการสินเชื่อเพื่อการพัฒนาที่อยู่อาศัยสำหรับผู้มีรายได้น้อยอย่างต่อเนื่อง เพื่อช่วยเหลือประชาชนให้สามารถเข้าถึงที่อยู่อาศัยของการเคหะแห่งชาติได้อย่างทั่วถึง โดยเฉพาะกลุ่มผู้มีรายได้น้อยและกลุ่มเปราะบาง ตามนโยบายของ รมว.พม. ซึ่งมุ่งเน้นให้ประชาชนทุกกลุ่มเข้าถึงโอกาสในการพัฒนาคุณภาพชีวิตอย่างเท่าเทียม ผ่านแนวคิด “ลดรายจ่าย สร้างรายได้ รีสตาร์ทชีวิตใหม่” เพื่อสร้างสังคมที่มั่นคงและยั่งยืน

การเคหะแห่งชาติปล่อยสินเชื่อเพื่อการพัฒนาที่อยู่อาศัยสำหรับผู้มีรายได้น้อย ตั้งแต่ปี 2563–2568 รวมทั้งสิ้น 2,326.237 ล้านบาท ครอบคลุมจำนวนผู้ได้รับสินเชื่อ 3,629 ราย โดยใช้วงเงินงบประมาณแล้วกว่าร้อยละ 94 ของกรอบงบประมาณทั้งหมด คงเหลือวงเงิน 149.285 ล้านบาท
ทั้งนี้แบ่งเป็นกลุ่มลูกค้าทั่วไป รวมจำนวน 3,173 ราย และกลุ่มเปราะบาง จำนวน 456 ราย ซึ่งรวมถึงผู้สูงอายุ คนพิการ และผู้มีรายได้น้อย สำหรับในปีงบประมาณ 2569 มีวงเงินงบประมาณในการปล่อยสินเชื่อ จำนวน 633.811 ล้านบาท ได้อนุมัติทำเช่าซื้อโครงการสินเชื่อแล้ว 64 ราย แบ่งเป็นกลุ่มลูกค้าทั่วไป 58 ราย และกลุ่มเปราะบาง 6 ราย เป็นจำนวนเงิน 39.350 ล้านบาท ซึ่งมีวงเงินงบประมาณคงเหลือ 594.461 ล้านบาท เพื่อรองรับการดำเนินงานในช่วงต่อไป
ผู้ว่าการการเคหะแห่งชาติ กล่าวเพิ่มเติมว่า “โครงการสินเชื่อเพื่อการพัฒนาที่อยู่อาศัยสำหรับผู้มีรายได้น้อยของการเคหะแห่งชาติ เป็นกลไกสำคัญในการขับเคลื่อนนโยบาย “พม. ใกล้คุณ” ของกระทรวง พม. ที่มุ่งเน้นการสร้างโอกาสและช่วยให้ประชาชนมีที่อยู่อาศัยเป็นของตนเองในราคาที่เหมาะสม เป็นการสร้างความมั่นคงในระยะยาว ช่วยลดภาระค่าใช้จ่ายด้านที่อยู่อาศัยและยกระดับคุณภาพชีวิตของประชาชน ตามวิสัยทัศน์ของการเคหะแห่งชาติ สร้างบ้าน สร้างสุข เพื่อคุณภาพชีวิตที่ดี”
ขอบคุณข้อมูลจาก thansettakij.com
ค่าเงินบาทเปิดเช้านี้ 10 พ.ย. “อ่อนค่าลงเล็กน้อย”ที่ระดับ 32.40 บาทต่อดอลลาร์

ค่าเงินบาทและเงินดอลลาร์ ยังคงเผชิญความเสี่ยงพร้อมเคลื่อนไหวได้ทั้งสองทิศทาง จนกว่าภาวะ US Government Shutdown จะสิ้นสุดลงและตลาดกลับมารับรู้รายงานข้อมูลเศรษฐกิจสำคัญสหรัฐ ควบคู่กับการปรับเปลี่ยนมุมมองของตลาดต่อแนวโน้มดอกเบี้ยเฟด
ค่าเงินบาทเปิดเช้านี้ 10 พ.ย. 2568 ที่ระดับ 32.40 บาทต่อดอลลาร์ “อ่อนค่าลงเล็กน้อย” จากระดับปิดสัปดาห์ก่อนหน้า ณ ระดับ 32.34 บาทต่อดอลลาร์
นายพูน พานิชพิบูลย์ นักกลยุทธ์ตลาดเงินตลาดทุน Krungthai GLOBAL MARKETS ธนาคารกรุงไทย เปิดเผยว่านับตั้งแต่ช่วงคืนวันศุกร์สัปดาห์ก่อนหน้า เงินบาท (USDTHB) พลิกกลับมาทยอยอ่อนค่าลงบ้าง หลังจากยังไม่สามารถแข็งค่าทะลุโซนแนวรับ 32.30 บาทต่อดอลลาร์
(แกว่งตัวในกรอบ 32.32-32.45 บาทต่อดอลลาร์) ตามจังหวะการย่อตัวลงของราคาทองคำ (XAUUSD) หนุนให้ผู้เล่นในตลาดต่างทยอยเข้าซื้อทองคำในจังหวะย่อตัว นอกจากนี้ การปรับตัวลดลงของราคาน้ำมันดิบในช่วงที่ผ่านมา ยังคงหนุนให้มีโฟลว์ธุรกรรมซื้อน้ำมันดิบ
กดดันให้เงินบาทอ่อนค่าลงจากโซนแนวรับ ก่อนที่ทั้งราคาทองคำจะทยอยรีบาวด์ขึ้นบ้าง ตามจังหวะการอ่อนค่าลงของเงินดอลลาร์ หลังรายงานดัชนีความเชื่อมั่นผู้บริโภคโดยมหาวิทยาลัยมิชิแกน ในเดือนพฤศจิกายน ปรับตัวลดลงสู่ระดับ 50.3 จุด แย่กว่าที่ตลาดคาด
หนุนให้ผู้เล่นในตลาดทยอยปรับเพิ่มความคาดหวังต่อแนวโน้มการลดดอกเบี้ยของเฟดลงบ้าง อย่างไรก็ดี ในช่วงเช้าของตลาดการเงินเอเชีย เงินดอลลาร์ทยอยรีบาวด์ขึ้นบ้าง ตามความหวังว่า ภาวะ US Government Shutdown อาจสิ้นสุดลงได้ในเร็ววันนี้
สัปดาห์ที่ผ่านมา เงินดอลลาร์พลิกกลับมาย่อตัวลง หลังรายงานข้อมูลตลาดแรงงานสหรัฐฯ จากภาคเอกชน ที่ออกมาแย่กว่าคาด ได้ทำให้ผู้เล่นในตลาดทยอยปรับเพิ่มความคาดหวังต่อแนวโน้มการลดดอกเบี้ยของเฟด
สำหรับในสัปดาห์นี้ เรามองว่า ควรรอติดตาม ถ้อยแถลงของบรรดาเจ้าหน้าที่เฟด รวมถึง จับตาแนวโน้มภาวะ US Government Shutdown อาจจบลงได้ในเร็ววัน เปิดทางให้ตลาดทยอยรับรู้รายงานข้อมูลเศรษฐกิจสำคัญของสหรัฐฯ
มุมมองเศรษฐกิจทั่วโลก
▪ ฝั่งสหรัฐฯ – เนื่องจากช่วงนี้ สหรัฐฯ ยังคงเผชิญกับ ภาวะ Government Shutdown ทำให้ รายงานข้อมูลเศรษฐกิจสำคัญของสหรัฐฯ ที่ควรจะประกาศในสัปดาห์นี้ อาทิ อัตราเงินเฟ้อ CPI ดัชนีราคาผู้ผลิต PPI และ ยอดค้าปลีก (Retail Sales) อาจถูกเลื่อนประกาศไปก่อน
ทำให้ผู้เล่นในตลาดจะรอประเมินแนวโน้มเศรษฐกิจสหรัฐฯ และทิศทางการดำเนินนโยบายการเงินของเฟด ผ่านถ้อยแถลงของบรรดาเจ้าหน้าที่เฟด รวมถึง รายงานข้อมูลเศรษฐกิจจากฝั่งภาคเอกชน อย่าง ดัชนีความเชื่อมั่นภาคธุรกิจขนาดเล็ก (NFIB Small Business Optimism) ในเดือนตุลาคม เป็นต้น (สำหรับผู้ใช้งาน Bloomberg Terminal สามารถดูข้อมูลเศรษฐกิจสหรัฐฯ แบบ Alternative Data ที่น่าสนใจ จาก WSL ALTE <GO>)
และนอกเหนือจากรายงานข้อมูลเศรษฐกิจดังกล่าว ผู้เล่นในตลาดจะรอติดตาม พัฒนาการของสถานการณ์การเมืองสหรัฐฯ หลังเริ่มมีข่าวว่า ภาวะ Government Shutdown อาจสิ้นสุดลงได้ในเร็ววันนี้ มิเช่นนั้น ผลกระทบต่อเศรษฐกิจอาจเพิ่มขึ้น หากภาวะดังกล่าวยืดเยื้อจนกระทบกับการใช้จ่าย การเดินทางในช่วงเทศกาล Thanksgiving (ปลายเดือนพฤศจิกายน) ไปจนถึง ช่วงเทศกาลคริสต์มาสและปีใหม่ (ปลายเดือนธันวาคม)
ฝั่งยุโรป – บรรดาผู้เล่นในตลาดจะรอประเมินแนวโน้มการดำเนินนโยบายการเงินของทั้งธนาคารกลางยุโรป (ECB) และธนาคารกลางอังกฤษ (BOE) ผ่านถ้อยแถลงของบรรดาเจ้าหน้าที่ ECB และ BOE รวมถึงรายงานข้อมูลเศรษฐกิจสำคัญ
อย่าง ข้อมูลตลาดแรงงานอังกฤษ ซึ่งอาจเป็นปัจจัยสำคัญที่ส่งผลต่อทิศทางการดำเนินนโยบายการเงินของ BOE ได้ โดยเราประเมินว่า หากตลาดแรงงานอังกฤษส่งสัญญาณชะลอตัวลงชัดเจนมากขึ้น เช่น ยอดการจ้างงานปรับตัวลดลง
ขณะเดียวกันอัตราการว่างงานก็เพิ่มสูงขึ้น ส่วนอัตราการเติบโตของค่าจ้างก็ชะลอตัวลงต่อเนื่อง ทาง BOE ก็มีโอกาสเดินหน้าลดดอกเบี้ย 25bps ในการประชุมเดือนธันวาคม หลังการประชุม BOE ล่าสุด ที่ BOE คงดอกเบี้ยตามคาด ณ ระดับ 4.00%
ทว่า มีจำนวนเจ้าหน้าที่ BOE มากขึ้น ที่สนับสนุนการลดดอกเบี้ย หรืออาจกล่าวได้ว่า การประชุม BOE มีลักษณะ Dovish Hold อนึ่ง ผู้เล่นในตลาดต่างประเมินว่า BOE มีโอกาสราว 71% ที่จะเดินหน้าลดดอกเบี้ย ในการประชุมเดือนธันวาคมนี้
▪ ฝั่งเอเชีย – ผู้เล่นในตลาดจะรอประเมินแนวโน้มเศรษฐกิจจีน ผ่านรายงานข้อมูลเศรษฐกิจสำคัญรายเดือน อาทิ ยอดค้าปลีก (Retail Sales) ยอดผลผลิตอุตสาหกรรม (Industrial Production) และยอดการลงทุนสินทรัพย์ถาวร (Fixed Assets Investment) รวมถึงข้อมูลตลาดแรงงาน อย่าง อัตราการว่างงาน ในเดือนตุลาคม โดยรายงานข้อมูลเศรษฐกิจจีนที่ทยอยออกมาดีกว่าคาด ก็อาจหนุนบรรยากาศในฝั่งตลาดการเงินจีนและช่วยหนุนเงินหยวนจีน (CNY) ได้บ้าง หลังสัปดาห์ก่อนหน้า อัตราเงินเฟ้อ CPI ของจีนในเดือนตุลาคม ได้ปรับตัวขึ้นสู่ระดับ 0.2%y/y สูงกว่าที่ตลาดคาดไว้ (โมเมนตัมรายเดือน %m/m ก็ออกมาที่ระดับ +0.2% สูงกว่าคาด เช่นกัน)
▪ ฝั่งไทย – ผู้เล่นในตลาดจะรอลุ้น รายงานดัชนีความเชื่อมั่นผู้บริโภค (Consumer Confidence) ในเดือนตุลาคม
สำหรับ แนวโน้มเงินบาท เราประเมินว่า เงินบาท (USDTHB) อาจเคลื่อนไหวในกรอบ Sideways ไปก่อนได้ โดยเฉพาะหลังโมเมนตัมการอ่อนค่าของเงินบาทได้ทยอยอ่อนกำลังลง ตามการอ่อนค่าลงบ้างของเงินดอลลาร์ หลังรายงานข้อมูลเศรษฐกิจสหรัฐฯ ล่าสุด จากภาคเอกชน ที่ออกมาแย่กว่าคาด ได้ทำให้ ผู้เล่นในตลาดทยอยปรับเพิ่มความคาดหวังต่อแนวโน้มการลดดอกเบี้ยของเฟดอีกครั้ง
อย่างไรก็ดี ทั้ง เงินดอลลาร์และเงินบาท ยังคงเผชิญความเสี่ยง Two-way risk (พร้อมเคลื่อนไหวได้ทั้งสองทิศทาง) ขึ้นกับการปรับเปลี่ยนมุมมองของผู้เล่นในตลาดต่อแนวโน้มดอกเบี้ยเฟด โดยในช่วงนี้อาจต้องรอติดตามถ้อยแถลงของบรรดาเจ้าหน้าที่เฟด
ควบคู่ไปกับรายงานข้อมูลเศรษฐกิจสหรัฐฯ จากภาคเอกชน จนกว่าภาวะ US Government Shutdown จะสิ้นสุดลง ซึ่งจะทำให้ เงินดอลลาร์ รวมถึงเงินบาทกลับมาเคลื่อนไหวในทิศทางที่ชัดเจนได้อีกครั้ง
และเนื่องจากเรายังคงมองว่า เฟดจะสามารถทยอยลดดอกเบี้ยได้ ตามสัญญาณการชะลอตัวลงการจ้างงานที่ชัดเจนมากขึ้น ทำให้เงินดอลลาร์มีแนวโน้มอ่อนค่าลงบ้างและช่วยหนุนการทยอยแข็งค่าขึ้นของเงินบาท ที่จะได้รับอานิสงส์จากช่วงไฮซีซั่นของการท่องเที่ยวอยู่แล้วในช่วงปลายปี (ปัจจัย Seasonality) ทั้งนี้ ควรจับตาทิศทางการเคลื่อนไหวของราคาทองคำ ซึ่งยังคงมีผลต่อแนวโน้มเงินบาทด้วยเช่นกัน
และหากอ้างอิงกลยุทธ์ Trend-Following เรามองว่า เงินบาทจะกลับเข้าสู่แนวโน้มอ่อนค่า อีกครั้ง เมื่อเงินบาทอ่อนค่าลงทะลุโซนแนวต้าน 32.65-32.75 บาทต่อดอลลาร์ (หรือปรับตัวขึ้นเหนือโซนเส้นค่าเฉลี่ย 30 สัปดาห์) ได้อย่างชัดเจน
ในส่วนของเงินดอลลาร์นั้น เรามองว่า เงินดอลลาร์อาจเคลื่อนไหวในกรอบ Sideways จนกว่าภาวะ US Government Shutdown จะสิ้นสุดลงและตลาดกลับมารับรู้รายงานข้อมูลเศรษฐกิจสำคัญสหรัฐฯ โดยเงินดอลลาร์จะผันผวนไปตามการปรับมุมมองของผู้เล่นในตลาดต่อแนวโน้มดอกเบี้ยเฟด ซึ่งต้องติดตามถ้อยแถลงของบรรดาเจ้าหน้าที่เฟดเช่นกัน
มองกรอบค่าเงินบาทสัปดาห์นี้ ที่ระดับ 32.20-32.70 บาท/ดอลลาร์
ส่วนกรอบเงินบาทในช่วง 24 ชั่วงโมงข้างหน้า คาดว่าจะอยู่ที่ระดับ 32.30-32.50 บาท/ดอลลาร์
ศูนย์วิจัยกสิกรไทยระบุว่าเงินบาทปรับตัวอยู่ที่ระดับประมาณ 32.36-32.38 บาทต่อดอลลาร์ฯ ในช่วงเช้าวันนี้ (9.47 น.) อ่อนค่าลงเล็กน้อยเมื่อเทียบกับระดับปิดตลาดปลายสัปดาห์ก่อนที่ 32.35 บาทต่อดอลลาร์ฯ
โดยเงินบาทอ่อนค่าลง สอดคล้องกับทิศทางเงินเยนที่อ่อนค่าลงจากความกังวลเรื่องแนวโน้มการใช้จ่ายของรัฐบาลญี่ปุ่น ซึ่งอาจทำให้ฐานะการคลังของญี่ปุ่นอ่อนแอลง นอกจากนี้ Sentiment ของเงินดอลลาร์ฯ ยังฟื้นตัวกลับมาได้บางส่วนท่ามกลางความคาดหวังว่า ภาวะชัตดาวน์ของสหรัฐฯ อาจกำลังสิ้นสุดลงในสัปดาห์นี้
สำหรับกรอบการเคลื่อนไหวของเงินบาทในวันนี้ ประเมินไว้ที่ 32.25-32.50 บาทต่อดอลลาร์ฯ ขณะที่ปัจจัยสำคัญที่ต้องติดตาม ได้แก่ ฟันด์โฟลว์ของต่างชาติ ทิศทางค่าเงินเอเชียและราคาทองคำในตลาดโลก รวมถึงสถานการณ์การชัตดาวน์ของสหรัฐฯ
ขอบคุณข้อมูลจาก thansettakij.com
ตบสาวยู-16 ยังได้ไปชิงแชมป์โลกแม้พ่ายฟิลิปปินส์ในนัดชิงอันดับ 5 เอเชีย

แม้ทัพลูกยางสาวไทยรุ่นอายุไม่เกิน 16 ปีจะพ่ายฟิลิปปินส์ 1-3 เซต ในการแข่งขันนัดชิงอันดับที่ 5 ในศึกวอลเลย์บอลหญิงยู-16 ชิงแชมป์เอเชีย 2025 แต่ยังได้ตั๋วไปแข่งขันยู-17 ชิงแชมป์โลก 2026 ในปีหน้าอย่างหวุดหวิด ในโควตาอันดับโลก
ปิดฉากลงไปแล้วสำหรับการแข่งขันวอลเลย์บอลหญิงรุ่นอายุไม่เกิน 16 ปีชิงแชมป์เอเชีย 2025 ที่กรุงอัมมาน ประเทศจอร์แดน โดยทัวร์นาเมนต์นี้ได้คัดเอา 4 ทีมที่ดีที่สุด บวกกับจีน(แชมป์วอลเลย์บอลหญิงยู-17 ชิงแชมป์โลก 2024) ไปแข่งขันยู-17 ชิงแชมป์โลก 2026 ที่ประเทศชิลี ในปีหน้าต่อไป
ปรากฏว่า ทีมที่ได้สิทธิ์ไปแข่งขันยู-17 ชิงแชมป์โลก 2026 โดยอัตโนมัติ ประกอบด้วย 1.เกาหลีใต้ แชมป์ยู-16 ชิงแชมป์เอเชีย 2025, 2.ไต้หวัน รองแชมป์ยู-16 ชิงแชมป์เอเชีย 2025, 3.จีน อันดับ 3 ยู-16 ชิงแชมป์เอเชีย 2025(ได้สิทธิ์ไปก่อนแล้ว จากการคว้าแชมป์ยู-17 ชิงแชมป์โลก 2024), 4. ญี่ปุ่น อันดับ 4 ยู-16 ชิงแชมป์เอเชีย 2025 และ 5.ฟิลิปปินส์ อันดับ 5 ศึกยู-16 ชิงแชมป์เอเชีย 2025
ส่วนทีมไทย แม้จะจบทัวร์นาเมนต์ด้วยการเป็นอันดับที่ 6 ในศึกยู-19 ชิงแชมป์เอเชีย 2025 หลังนัดชิงอันดับ 5 พ่ายต่อฟิลิปปินส์ 1-3 เซต ทว่ายังได้สิทธิ์ไปแข่งขันยู-17 ชิงแชมป์โลก 2026 เช่นกันในโควตาอันดับโลก
นับเป็นครั้งที่ 2 ติดต่อกันที่ทัพตบเยาวชนสาวไทย จะได้สิทธิ์ไปแข่งขันยู-17 ชิงแชมป์โลก ต่อจากหนก่อนซึ่งจัดขึ้นเป็นครั้งแรกที่ประเทศเปรู เมื่อปี 2024 ซึ่งไทยจบทัวร์นาเมนต์ด้วยอันดับ 11 เท่ากับว่าในศึกยู-17 ชิงแชมป์โลก 2026 ที่ประเทศชิลีในปีหน้า จะมีตัวแทนจากทวีปเอเชียร่วมแข่งขัน 6 ทีมด้วยกัน
ส่วนอีก 18 ทีมจากทวีปอื่นที่ได้สิทธิ์แข่งขันยู-17 ชิงแชมป์โลก 2026 มีดังนี้ ชิลี(เจ้าภาพ), เปรู, บราซิล, เวเนซูเอลา, อาร์เจนตินา, สหรัฐอเมริกา, โดมินิกัน, เปอร์โตริโก, เม็กซิโก, อียิปต์, ตูนิเซีย, อัลจีเรีย, สาธารณรัฐเชก, อิตาลี, โปแลนด์, ตุรกี, โครเอเชีย และ สเปน
ขอบคุณข้อมูลจาก siamsport.co.th
4 “เส้นตายสีแดง” ห้ามแตะ! ผู้เชี่ยวชาญเตือน อดนอนถึงระดับนี้ หัวใจเสี่ยงหยุดเต้นเฉียบพลัน

การอดนอนถึงระดับไหนที่อันตราย? ผู้เชี่ยวชาญชี้ 4 “เส้นตายสีแดง” ที่ทุกคนไม่ควรแตะต้อง
ในความเป็นจริงแล้ว ก่อนที่จะเกิดผลลัพธ์ที่น่าเศร้าขึ้น ร่างกายได้ส่งสัญญาณเตือนจำนวนนับไม่ถ้วน เพียงแต่เรามองข้ามหรือไม่ให้ความสำคัญกับมัน
เมื่อการอดนอนกลายเป็นภัยคุกคามต่อชีวิต
ตามบทความรวบรวมล่าสุดในหนังสือพิมพ์ (Life Times) พร้อมความคิดเห็นของผู้เชี่ยวชาญด้านหัวใจและหลอดเลือดหลายท่าน การอดนอนเป็นเวลานานอาจทำให้ ความเสี่ยงต่อภาวะหัวใจหยุดเต้นเฉียบพลันเพิ่มสูงขึ้น โดยเฉพาะอย่างยิ่งเมื่อมีสัญญาณอันตรายดังต่อไปนี้
นายแพทย์ฮั่ว เซี่ยวชวน รองหัวหน้าแผนกโรคหลอดเลือดสมอง โรงพยาบาลอันเจิ้น (มหาวิทยาลัยการแพทย์ปักกิ่ง) กล่าวว่า: “การอดนอนเองอาจไม่ได้ทำให้เกิดภาวะหัวใจหยุดเต้นเฉียบพลันโดยตรง แต่มันเป็นตัวเร่งให้ปัจจัยเสี่ยงโรคหัวใจและหลอดเลือดปะทุขึ้น เมื่อร่างกายตกอยู่ในสี่ภาวะด้านล่างนี้ คุณจำเป็นต้องหยุดงานทั้งหมดและพักผ่อนทันที”
4 “เส้นตายสีแดง” ที่ต้องระวัง:
- นอนน้อยกว่า 4 ชั่วโมงต่อคืนติดต่อกันเกิน 3 วัน
- เทียบเท่ากับการบังคับให้หัวใจทำงานด้วย “ความเร็วสูง” เป็นเวลา 72 ชั่วโมงโดยไม่หยุดพัก ทุกการเต้นของหัวใจคือการหดตัวและสึกหรอของเซลล์กล้ามเนื้อหัวใจ ในการนอนหลับปกติ เซลล์เหล่านี้สามารถฟื้นตัวได้ถึง 40% แต่เมื่อขาดการนอนหลับ กระบวนการซ่อมแซมเกือบจะหยุดลง
- งานวิจัยแสดงให้เห็นว่า ในสภาวะนี้ ความต้องการออกซิเจนของหัวใจเพิ่มขึ้น 3 เท่า ในขณะที่ความเสี่ยงของการหดตัวของหลอดเลือดเพิ่มขึ้น 5 เท่า
- อดนอนตลอด 24 ชั่วโมงโดยไม่มีการนอนชดเชย
- การทดลองในคนที่มีสุขภาพดีแสดงให้เห็นว่า หลังจากการอดนอนหนึ่งคืน ความดันโลหิตอาจเพิ่มขึ้น 15-20 mmHg และความหนืดของเลือดเพิ่มขึ้น 20% ในเวลานั้น เพียงแค่การปีนบันไดหนึ่งชั้นก็อาจทำให้หัวใจเกินขีดจำกัดความทนทาน และเพิ่มความเสี่ยงต่อภาวะกล้ามเนื้อหัวใจตายได้
- นอนน้อยกว่า 6 ชั่วโมงต่อวันเป็นระยะเวลานาน
- การนอนน้อยร่วมกับโรคเรื้อรัง เช่น ความดันโลหิตสูง เบาหวาน จะทำให้เกิดความเสียหายต่อเยื่อบุหลอดเลือด และเพิ่มปัจจัยการอักเสบในเลือด ทำให้ คราบไขมันในหลอดเลือด (Plaque) ก่อตัวเร็วขึ้นและเปราะบางขึ้น หากควบคู่ไปกับการสูบบุหรี่ โรคอ้วน หรือการรับประทานอาหารรสเค็มจัด/เผ็ดจัด คราบไขมันอาจแตกออก ก่อให้เกิดภาวะหลอดเลือดหัวใจอุดตันเฉียบพลัน ซึ่งเป็นสาเหตุหลักของภาวะหัวใจหยุดเต้นเฉียบพลัน
- อดนอนร่วมกับความเครียดจากงานหรือการออกกำลังกายที่หนักหน่วง
- หลังจากการอดนอน ระบบประสาทซิมพาเทติกจะอยู่ในสภาวะตื่นตัวอยู่เสมอ หากยังคงได้รับแรงกดดัน ความเครียด หรือการออกกำลังกายที่ต้องใช้ความพยายาม ระดับฮอร์โมนนอร์อะดรีนาลีน (สารกระตุ้นหัวใจ) จะเพิ่มสูงขึ้น อย่างรวดเร็ว ซึ่งอาจนำไปสู่ภาวะหัวใจเต้นผิดจังหวะที่เป็นอันตรายได้ง่าย
เมื่อหัวใจ “วูบ” ไปหนึ่งจังหวะ – สัญญาณที่ไม่ควรมองข้าม
หลายคนเมื่ออดนอนจะรู้สึกว่าหัวใจ “วูบ” หรือ “เต้นผิดจังหวะ” ไปหนึ่งครั้ง ตามที่ นายแพทย์เยือง หวี่ (Dương Vĩ) รองหัวหน้าแผนกทั่วไป โรงพยาบาลซวนหวู่ (มหาวิทยาลัยการแพทย์ปักกิ่ง) กล่าวว่า ปรากฏการณ์นี้เรียกว่า “ภาวะหัวใจเต้นผิดจังหวะก่อนกำหนด” (early beat/ ngoại tâm thu) ซึ่งเป็นรูปแบบหนึ่งของการเต้นของหัวใจผิดจังหวะที่ค่อนข้างพบได้บ่อย
มี “ภาวะหัวใจเต้นผิดจังหวะก่อนกำหนด” สองประเภท:
- “ชนิดทำงาน : เป็นอาการที่มักพบในคนหนุ่มสาวและมีสุขภาพดี เกิดจากความเครียด ความเหนื่อยล้า การใช้คาเฟอีน แอลกอฮอล์ บุหรี่ หรือการอดนอนเป็นเวลานาน มักไม่เป็นอันตราย
- “ชนิดพยาธิสภาพ” : จะเกิดขึ้นบ่อยครั้ง ทำให้เกิดอาการใจสั่น เจ็บหน้าอก หายใจลำบาก หากบันทึกคลื่นไฟฟ้าหัวใจ 24 ชั่วโมง (Holter) พบว่ามีการเต้นผิดจังหวะหลายหมื่นครั้งต่อวัน จำเป็นต้องได้รับการรักษาอย่างเร่งด่วน
ผู้เชี่ยวชาญเตือนว่า ทุกคนไม่ควรอดนอน หลีกเลี่ยงสารกระตุ้น เลิกบุหรี่ จำกัดแอลกอฮอล์ โดยเฉพาะอย่างยิ่ง ทุกคนควรรักษาการออกกำลังกายเบา ๆ รับประทานอาหารอ่อน ๆ เสริมปลา ผักสีเขียว และผลไม้สด ผู้ที่มีอาการเริ่มต้นควรตรวจสุขภาพหัวใจเป็นประจำเพื่อตรวจหาและรักษาได้ทันท่วงที
หมายเหตุสำคัญ: หากหลังจากการอดนอน คุณรู้สึกอ่อนเพลียอย่างรุนแรง, นอนหลับมากแค่ไหนก็ไม่ฟื้น, มีอาการเจ็บแน่นหน้าอกคล้ายถูกกดทับ, ปวดร้าวไปที่ไหล่ซ้ายหรือกราม, เหงื่อออกเย็น, มือเท้าเย็น, คลื่นไส้, หายใจลำบาก, ให้หยุดพักทันทีและโทรเรียกรถพยาบาล นี่อาจเป็นสัญญาณของ ภาวะกล้ามเนื้อหัวใจตายเฉียบพลัน การไปโรงพยาบาลช้าไปเพียงไม่กี่นาทีก็อาจเป็นอันตรายถึงชีวิตได้
7 นิสัยช่วยผู้ที่ต้องอดนอนเป็นประจำในการปกป้องหัวใจ
ตามที่ นายแพทย์ป๋อ ซื่อหนิง (Bạc Thế Ninh) หัวหน้าแผนกผู้ป่วยหนัก โรงพยาบาลมหาวิทยาลัยปักกิ่ง ประเทศจีน กล่าวว่า หากคุณจำเป็นต้องอดนอนเนื่องจากหน้าที่การงาน คุณควรปฏิบัติตามนิสัยเหล่านี้เพื่อลดความเสียหายต่อหัวใจและหลอดเลือด:
- การอดนอนอย่างมีวินัย: กำหนดเวลาทำงานและเวลานอนที่แน่นอน แม้ในวันหยุดสุดสัปดาห์ เพื่อช่วยให้นาฬิกาชีวิตคงที่
- ไม่กินอาหารมื้อดึก: การกินมื้อดึกทำให้การเผาผลาญน้ำตาลและไขมันผิดปกติ เพิ่มความเสี่ยงต่อโรคเบาหวานและโรคอ้วน หากหิวเกินไป ควรกินอาหารว่างเบา ๆ เช่น ธัญพืชไม่ขัดสี ไข่ นม หรือผลไม้
- ไม่นั่งนาน: ทุก 2-3 ชั่วโมง ควรลุกขึ้นเดิน 10 นาที เพื่อหลีกเลี่ยงภาวะเลือดคั่งและลิ่มเลือด
- เพิ่มการงีบหลับสั้น ๆ: แม้จะงีบหลับเพียง 10-20 นาทีในตอนกลางวันก็สามารถช่วยให้ร่างกายฟื้นฟูพลังงานได้
- กินอาหารที่มีสารต้านอนุมูลอิสระสูง: ผักและผลไม้สีเข้ม (กะหล่ำปลีสีม่วง บลูเบอร์รี่ สตรอเบอร์รี่) ชาเขียว ถั่ววอลนัท ช่วยลดความเสียหายจากปฏิกิริยาออกซิเดชันหลังจากการอดนอน
- ออกกำลังกายปานกลาง: หลังจากการนอนชดเชยและฟื้นตัวแล้ว ควรออกกำลังกายเบา ๆ เพื่อปรับปรุงการไหลเวียนโลหิตและลดความเครียด
- ดื่มน้ำให้เพียงพอ: การอดนอนทำให้ร่างกายสูญเสียน้ำ ดังนั้นควรดื่มน้ำเปล่า ชาจืด น้ำผึ้ง น้ำพุทรา หรือซุปถั่วเขียวเพื่อช่วยลดความร้อนและขับสารพิษ
ขอบคุณข้อมูลจาก sanook.com
Plain English เทคนิคของการสื่อสารภาษาอังกฤษที่เรียบง่ายแต่ทรงพลัง

บทความนี้นำเสนอแนวคิด Plain English ว่าคืออะไร ใช้งานอย่างไร ซึ่งเป็นวิธีใช้ภาษาอังกฤษที่เรียบง่ายและตรงประเด็น เหมาะอย่างยิ่งสำหรับผู้ที่กำลัง เรียนภาษาอังกฤษ ในทุกระดับ โดยเฉพาะผู้ที่เพิ่ง เริ่มต้นเรียนภาษาอังกฤษ หรือเรียนภาษาอังกฤษไม่มีพื้นฐานเลย เนื้อหาครอบคลุมทั้งความหมายของ Plain English ประโยชน์ในบริบทการสื่อสารจริง และตัวอย่างจากธุรกิจและชีวิตประจำวัน ที่แสดงให้เห็นว่าภาษาอังกฤษที่ชัดเจนและเข้าใจง่ายนั้นมีพลังเพียงใด Plain English จึงไม่ใช่แค่การใช้คำศัพท์ง่าย ๆ เท่านั้น แต่เป็นทักษะที่ช่วยให้คุณสื่อสารได้มีประสิทธิภาพ และเหมาะสำหรับผู้ที่ เรียนภาษาอังกฤษด้วยตัวเอง หรือ เรียนภาษาอังกฤษออนไลน์ Plain English เป็นแนวทางที่คุณควรรู้หากต้องการ เรียนภาษาอังกฤษ ให้ได้ผล เพราะจะทำให้คุณสนุกกับการเริ่มต้นใช้ภาษาอังกฤษและต่อยอดสู่ทักษะภาษาอังกฤษในระดับสูงขึ้นได้ตามลำดับ
1) Plain English คืออะไร
Plain English คือ การใช้ภาษาอังกฤษที่เน้นความเรียบง่าย ชัดเจน และตรงประเด็น โดยหลีกเลี่ยงคำศัพท์ยาก โครงสร้างประโยคที่ซับซ้อน และภาษาทางการเกินจำเป็น หลายคนที่ เรียนภาษาอังกฤษ มักเข้าใจว่าต้องใช้คำหรูหรือศัพท์ยากถึงจะดูเก่ง แต่ในชีวิตจริงแล้วการสื่อสารให้คนอื่นเข้าใจได้ชัดเจนและรวดเร็วต่างหากคือทักษะที่แท้จริงของการใช้ภาษา
Plain English ไม่ได้หมายถึงภาษาที่ “ง่ายจนดูไม่มีความเป็นทางการ” แต่คือการเลือกใช้คำและประโยคที่เหมาะสมกับผู้อ่านหรือผู้ฟัง เช่น แทนที่จะใช้คำว่า “endeavor” อาจใช้ “try” แทน ซึ่งสื่อสารได้ตรงและเข้าใจง่ายกว่า นี่คือสิ่งที่ผู้ เรียนภาษาอังกฤษ ทุกคนควรฝึก โดยเฉพาะผู้ที่เพิ่ง เริ่มต้นเรียนภาษาอังกฤษ หรือผู้ที่ เรียนภาษาอังกฤษไม่มีพื้นฐานเลย การเริ่มจากการเข้าใจและฝึกใช้ Plain English จะช่วยให้คุณก้าวหน้าเร็วขึ้น และไม่รู้สึกท้อเมื่อเจอกับภาษาอังกฤษที่ดูยุ่งยาก
2) ประโยชน์ของ Plain English กับการสื่อสารในชีวิตจริง
การ เรียนภาษาอังกฤษ ไม่ใช่แค่เรื่องการรู้คำศัพท์หรือไวยากรณ์ แต่คือการสื่อสารให้คนเข้าใจ ดังนั้น Plain English จึงเป็นเครื่องมือสำคัญที่ช่วยลดช่องว่างระหว่าง “รู้ภาษา” กับ “ใช้ภาษา” ได้อย่างแท้จริง
ประโยชน์ของการใช้ Plain English มีมากมาย เช่น:
- เข้าใจง่าย: โดยเฉพาะเมื่อเขียนหรือพูดกับผู้ที่ไม่ใช่เจ้าของภาษา
- ประหยัดเวลา: ผู้ฟังหรือผู้อ่านไม่ต้องเสียเวลาตีความ
- ลดข้อผิดพลาดในการสื่อสาร: เหมาะกับการใช้งานในชีวิตประจำวัน เช่น การส่งอีเมล การแจ้งงาน หรือการพูดคุยทั่วไป
- ช่วยให้การ เรียนภาษาอังกฤษ มีประสิทธิภาพมากขึ้น: ผู้เรียนสามารถโฟกัสที่การใช้จริง ไม่ติดกับคำศัพท์ที่ไม่จำเป็น
คนที่ เรียนภาษาอังกฤษด้วยตัวเอง หรือ เรียนภาษาอังกฤษออนไลน์ มักไม่มีครูคอยแก้ไขให้ทันที เทคนิคใช้ Plain English จึงช่วยให้ผู้เรียนมั่นใจมากขึ้นในการสื่อสาร เพราะรู้ว่าภาษาที่ใช้จะถูกเข้าใจโดยคนทั่วไปอย่างแน่นอน
3) ใครใช้ Plain English บ้าง? ตัวอย่างจริงจากโลกธุรกิจและชีวิตประจำวัน
Plain English ไม่ใช่แค่เรื่องในห้อง เรียนภาษาอังกฤษ เท่านั้น แต่องค์กรทั่วโลกใช้หลักการนี้ในการสื่อสารกับลูกค้า พนักงาน และสาธารณชน เช่น:
- องค์กรภาครัฐในออสเตรเลีย สหรัฐฯ และสหราชอาณาจักร ใช้ Plain English ในการเขียนเอกสารราชการ เพื่อให้ประชาชนเข้าใจข้อมูลสำคัญ
- บริษัทใหญ่ระดับโลกอย่าง Google และ Microsoft ใช้ Plain English ในคู่มือสินค้า คำแนะนำการใช้งาน และอีเมลถึงลูกค้า
- โรงพยาบาลและองค์กรสาธารณสุข ใช้ Plain English ในเอกสารเกี่ยวกับสุขภาพ เพื่อให้ประชาชนเข้าใจได้แม้ไม่มีพื้นฐานทางการแพทย์
แม้แต่ในชีวิตประจำวัน หากคุณเขียนอีเมลถึงเพื่อนร่วมงานหรือสื่อสารกับลูกค้าต่างชาติ การใช้ Plain English จะทำให้คุณดูเป็นมืออาชีพมากขึ้นและเข้าใกล้เป้าหมายของการ เรียนภาษาอังกฤษ ได้เร็วขึ้น
4) ตัวอย่างการใช้ภาษาอังกฤษแบบ Plain English
Plain English ได้รับความนิยมและใช้ในวงการสื่อสารสมัยใหม่ ไม่ว่าจะเป็น UX Writing, เว็บไซต์, เอกสารราชการ หรืออีเมลธุรกิจ เพราะช่วยให้คนอ่านเข้าใจไวขึ้น ไม่ต้องตีความหลายชั้น ลดโอกาสสื่อสารผิดพลาด มาดูตัวอย่างประโยคต่อไปนี้กัน
1.
Not-plain English
- We acknowledge the receipt of your correspondence and shall endeavour to respond at the earliest opportunity.
Plain English
- Thanks for your message. We’ll reply as soon as we can.
2.
Not-plain English
- Should you require further assistance, please do not hesitate to contact us.
Plain English
- If you need more help, just let us know.
3.
Not-plain English
- The utilization of this system may result in the enhancement of workflow efficiency.
Plain English
- Using this system can help you work faster.
จะเห็นว่าเราสามารถสื่อความหมายเดียวกันได้ด้วยประโยคที่ง่ายกว่า สั้นกว่า เข้าใจได้เร็วกว่า ควรดูตัวอย่างเหล่านี้เป็นแรงบันดาลใจเพราะแสดงให้เห็นว่าแม้จะไม่ได้พูดภาษาอังกฤษขั้นสูง แต่การใช้ภาษาที่ “เข้าใจได้” คือสิ่งที่ทำให้คุณสื่อสารได้จริง
ขอบคุณข้อมูลจาก engduothailand.com
นวัตกรรมใหม่ในไทย miRNA ตรวจมะเร็งกระเพาะอาหาร ด้วยชุดตรวจเลือด
- บริษัท Mirxes เปิดตัว GASTROClear™ นวัตกรรมชุดตรวจเลือดที่ใช้เทคโนโลยี miRNA สำหรับคัดกรองมะเร็งกระเพาะอาหารในระยะเริ่มต้น
- ชุดตรวจเลือดสำหรับมะเร็งกระเพาะอาหารนี้ได้รับการรับรองจากสำนักงานคณะกรรมการอาหารและยา (อย.) ของไทยแล้วจ
- Mirxes ได้ลงทุนเชิงกลยุทธ์ในประเทศไทย โดยมีเป้าหมายเพื่อพัฒนาให้ไทยเป็นศูนย์กลางด้านนวัตกรรมเทคโนโลยีชีวภาพและการตรวจวินิจฉัยโรคมะเร็งด้วย miRNA
ดร.โจว ลี่หาน ผู้ร่วมก่อตั้งและซีอีโอของ Mirxes บริษัทเทคโนโลยี RNA กล่าวว่า Mirxes มุ่งมั่นพัฒนาโซลูชันการตรวจหามะเร็งระยะเริ่มต้นให้เข้าถึงได้ ด้วยแพลตฟอร์มการตรวจหาไมโครอาร์เอ็นเอที่เป็นกรรมสิทธิ์และเป็นผู้นำในอุตสาหกรรม ซึ่งได้พัฒนา GASTROClear™ การตรวจเลือดที่ได้รับการรับรองจากหน่วยงานกำกับดูแล สำหรับการคัดกรองมะเร็งกระเพาะอาหาร
โดยบริษัทประสบความสำเร็จในการเสนอขายหุ้น IPO. ในตลาดหลักทรัพย์ฮ่องกง ในเดือนพฤษภาคม 2568 ทำให้ Mirxes กลายเป็นบริษัทเทคโนโลยีชีวภาพระดับยูนิคอร์นแห่งแรกของเอเชียตะวันออกเฉียงใต้ และได้ลงทุนเชิงกลยุทธ์รุกตลาดในประเทศไทย สู่อุตสาหกรรมเทคโนโลยีชีวภาพ
ล่าสุด ได้รับการรับรองจากสำนักงานคณะกรรมการอาหารและยา (อย.) นับเป็นก้าวสำคัญและตอกย้ำแนวทางนวัตกรรมด้วยเทคโนโลยี miRNA ที่ถือได้ว่าเป็นนวัตกรรมเทคโนโลยีชีวภาพแนวหน้า ช่วยให้สามารถตรวจพบมะเร็งได้ตั้งแต่ระยะเริ่มต้นและสามารถรักษาได้เร็วที่สุด
“เรามุ่งมั่นที่จะเปลี่ยนแปลงวิธีการตรวจพบและจัดการมะเร็งในประเทศไทย ขณะเดียวกันก็ปูทางไปสู่การเติบโตของ Mirxes ทั่วภูมิภาคเอเชียตะวันออกเฉียงใต้ และไม่ได้จำกัดอยู่แค่ GASTROClear™ เท่านั้น”
เป้าหมายเชิงพาณิชย์ในระยะสั้น ได้แก่
• การวิจัยและพัฒนา: การจัดตั้งศูนย์ที่ทันสมัยสำหรับการวินิจฉัยโรคมะเร็งด้วย miRNA และการรักษาเฉพาะบุคคลในประเทศไทย
• การพัฒนาบุคลากร: การร่วมมือกับสถาบันในประเทศไทยเพื่อฝึกอบรม การให้ทุนการศึกษา และโอกาสในการทำวิจัยที่ครอบคลุม
• การส่งออกระดับภูมิภาค: การพัฒนาประเทศไทยให้เป็นศูนย์กลางชั้นนำด้านนวัตกรรมเทคโนโลยีชีวภาพ เพื่อส่งออกความเชี่ยวชาญและบุคลากรที่มีความสามารถไปทั่วเอเชียตะวันออกเฉียงใต้
ดร.โจว กล่าวว่า นอกจากนี้ Mirxes ยังได้พัฒนาชุดตรวจทางคลินิกที่มีประสิทธิภาพ ทั้งแบบเดี่ยวและแบบหลายมะเร็งสำหรับมะเร็งที่มีอุบัติการณ์สูง ได้แก่ มะเร็งปอด มะเร็งลำไส้ใหญ่และมะเร็งทวารหนัก มะเร็งตับ และมะเร็งเต้านม โดยร่วมมือกับสถาบันการศึกษาและสถาบันทางคลินิกที่มีชื่อเสียงทั่วโลก
การขยายธุรกิจเชิงกลยุทธ์ของ Mirxes สะท้อนให้เห็นอย่างชัดเจนถึงความมุ่งมั่นอย่างไม่ลดละ ในการทำให้การดูแลสุขภาพเชิงป้องกันที่มีคุณภาพ สามารถเข้าถึงได้ทั่วภูมิภาคเอเชียแปซิฟิก และการสร้างฐานที่มั่นคงในประเทศไทย ไม่เพียงแต่ช่วยแก้ไขปัญหาสาธารณสุขเฉพาะหน้าเท่านั้น แต่ยังสร้างอนาคตที่การตรวจพบมะเร็งตั้งแต่ระยะเริ่มต้น ช่วยเปลี่ยนแปลงผลลัพธ์ของผู้ป่วยในประเทศและทั่วภูมิภาคเอเชียตะวันออกเฉียงใต้ได้อย่างมาก
ขอบคุณข้อมูลจาก thansettakij.com
6 ต้นไม้ดูดความชื้น ตัวช่วยบ้านแห้งสบายไม่อับ ป้องกันเชื้อรา ฟอกอากาศสะอาด

แม้กระถางต้นไม้เล็กๆ จะไม่สามารถเปลี่ยนสภาพอากาศได้ แต่สามารถช่วยให้บ้านของคุณแห้งสบายขึ้นในฤดูฝน เพราะฤดูฝนมักมาพร้อมความชื้นสูงในอากาศ ส่งผลให้เกิดเชื้อราและกลิ่นอับได้ง่าย หากไม่อยากเปิดเครื่องลดความชื้นตลอดเวลา ลองใช้วิธีธรรมชาติด้วยการปลูกต้นไม้ดูดความชื้นแทน ซึ่งไม่เพียงช่วยกรองอากาศ แต่ยังเพิ่มความสดชื่นและความสวยงามให้บ้านได้อีกด้วย
1. เฟิร์น – นักดูดความชื้นมืออาชีพ
เฟิร์น เป็นหนึ่งในพืชที่มีความสามารถในการดูดซับความชื้นได้ดีเยี่ยม เหมาะสำหรับพื้นที่อับชื้นและแสงน้อย ใบและรากของเฟิร์นสามารถดูดซับไอน้ำในอากาศ ช่วยปรับสมดุลความชื้นภายในบ้านได้ตามธรรมชาติ อีกทั้งยังช่วยกรองสารฟอร์มาลดีไฮด์ (Formaldehyde) และสารพิษจากสีหรือวัสดุตกแต่งภายใน ทำให้อากาศในบ้านสะอาดยิ่งขึ้น
แนะนำให้วางกระถางเฟิร์นในห้องน้ำ ห้องครัว หรือบริเวณใกล้หน้าต่างที่มีความชื้นสูง สีเขียวสดของใบยังช่วยให้บ้านดูมีชีวิตชีวาในวันที่ฝนพรำ

2. เดหลี – เครื่องฟอกอากาศธรรมชาติ
เดหลี หรือ Peace Lily เป็นพืชที่มีคุณสมบัติในการดูดซับความชื้นได้ดี พร้อมฟอกอากาศไปในตัว เดหลีสามารถดูดซับไอน้ำในอากาศผ่านทางใบ และช่วยยับยั้งเชื้อรา แบคทีเรียที่ก่อกลิ่นไม่พึงประสงค์ นอกจากนี้ องค์การ NASA ยังจัดให้เดหลีเป็นหนึ่งในพืชฟอกอากาศที่มีประสิทธิภาพสูงสุด เหมาะกับบ้านที่มีอุปกรณ์อิเล็กทรอนิกส์จำนวนมาก
ด้วยดอกสีขาวเล็กเรียบง่ายและสื่อถึงความบริสุทธิ์ จึงเหมาะสำหรับตกแต่งห้องนั่งเล่นหรือห้องนอน และยังดูแลง่ายแม้อยู่ในที่แสงน้อย

3. พลูด่าง – พืชสารพัดประโยชน์
พลูด่าง เป็นอีกหนึ่งพืชยอดนิยมที่ปลูกง่ายและช่วยดูดความชื้นได้ดีเยี่ยม ทั้งทางใบและราก พลูด่างยังสามารถดูดซับคาร์บอนไดออกไซด์ (CO₂) รวมถึงสารพิษอย่างเบนซีนและฟอร์มาลดีไฮด์ได้อย่างมีประสิทธิภาพ
สามารถปลูกได้ทั้งในน้ำและในดิน หรือแขวนประดับตามชั้นวางหนังสือและริมหน้าต่าง เพิ่มความเขียวสดใสและบรรยากาศสบายตาในบ้าน

4. ลิ้นมังกร – ดูดชื้นกลางวัน ปล่อยออกซิเจนกลางคืน
ลิ้นมังกร หรือ Snake Plant มีคุณสมบัติเด่นในการปรับสมดุลความชื้นภายในห้อง กลางวันดูดซับไอน้ำ ส่วนกลางคืนจะปล่อยออกซิเจนออกมา เหมาะอย่างยิ่งสำหรับห้องนอนในช่วงอากาศชื้นจัด ใบหนาและอุ้มน้ำได้ดี ทำให้ไม่ต้องรดน้ำบ่อย
ตามหลักฮวงจุ้ย ลิ้นมังกรยังเป็นสัญลักษณ์ของการปกป้องและโชคลาภ จึงนิยมวางในห้องน้ำหรือห้องนอน เพื่อให้บ้านสะอาดและเพิ่มพลังบวก

5. ว่านหางจระเข้ – ดูดชื้นและฟื้นฟูผิว
ว่านหางจระเข้ ไม่เพียงมีสรรพคุณในการดูแลผิว แต่ยังช่วยดูดซับความชื้นในอากาศได้ดี ใบอวบน้ำของมันสามารถดูดและเก็บไอน้ำไว้ เมื่ออากาศแห้งจะค่อยๆ ปล่อยออกมาเพื่อรักษาความชื้นให้คงที่
ปลูกง่าย ทนทาน ไม่ต้องรดน้ำบ่อย เหมาะสำหรับคนไม่มีเวลา และยังสามารถนำเนื้อว่านไปใช้เป็นเจลบำรุงผิวหรือหลังออกแดดได้อีกด้วย

6. สับปะรดประดับ – พืชสีสวยช่วยดูดชื้น
สับปะรดประดับ เป็นไม้ที่เติบโตได้ดีในพื้นที่อับชื้นและแสงน้อย จึงเหมาะสำหรับวางในห้องน้ำหรือห้องครัว ใบรูปทรงคล้ายกรวยช่วยกักเก็บน้ำและลดความชื้นในอากาศได้อย่างมีประสิทธิภาพ
นอกจากช่วยดูดชื้นแล้ว ยังช่วยดูดซับสารพิษ เช่น โทลูอีนและฟอร์มาลดีไฮด์ อีกทั้งยังมีสีสันสดใส เพิ่มความมีชีวิตชีวาให้กับบ้าน และมอบบรรยากาศสไตล์ทรอปิคอลที่ผ่อนคลาย

ขอบคุณข้อมูลจาก sanook.com
ราคาทองตามประกาศของสมาคมค้าทองคำ ประจำวันที่ 10/11/2568
| ชนิดทอง | ราคารับซื้อ กรัมละ | ราคารับซื้อ บาทละ | ราคาขาย บาทละ |
|---|---|---|---|
| ทองคำแท่ง 96.5% | n/a | 61,900.00 | 62,000.00 |
| ทองรูปพรรณ 96.5% | 4,001.00 | 60,655.16 | 62,800.00 |
| ทองรูปพรรณ 90% | 3,600.90 | 54,589.64 | n/a |
| ทองรูปพรรณ 80% | 3,200.80 | 48,524.13 | n/a |
| ทองรูปพรรณ 50% | 1,800.45 | 27,294.82 | n/a |
| ทองรูปพรรณ 40% | 1,400.35 | 21,229.31 | n/a |
| ทองรูปพรรณ 99.99% | 4,146.11 | 62,855.03 | n/a |
ราคาน้ำมันประจำวัน ราคาน้ำมันประจำวันที่ 10/11/2568
ปตท. | บางจาก | เชลล์ | คาลเท็กซ์ | ไออาร์พีซี | พีที | ซัสโก้ | เพียว | พรุ่งนี้ | |
|---|---|---|---|---|---|---|---|---|---|
| แก๊สโซฮอล์ 95 | 31.85 | 31.85 | 32.35 | 31.85 | 31.85 | 31.85 | 31.85 | 31.85 | 31.85 |
| แก๊สโซฮอล์ 91 | 31.48 | 31.48 | 31.98 | 31.48 | 31.48 | 31.48 | 31.48 | 31.48 | 31.48 |
| แก๊สโซฮอล์ E20 | 29.64 | 29.64 | 30.14 | 29.64 | – | 29.64 | 29.64 | 29.64 | 29.64 |
| แก๊สโซฮอล์ E85 | 27.59 | 27.59 | – | – | – | – | – | – | 27.59 |
| แก๊สโซฮอล์ 95 พรีเมี่ยม | 40.04 | 49.54 | 49.84 | – | – | – | – | – | 40.04 |
| เบนซิน 95 | 40.14 | – | – | 49.51 | – | 40.64 | 40.29 | – | 40.14 |
| ดีเซล | 30.94 | 30.94 | 30.94 | 30.94 | 30.94 | 30.94 | 30.94 | 30.94 | 30.94 |
| ดีเซลพรีเมี่ยม | 43.44 | 45.64 | 49.84 | 45.64 | – | – | – | – | 43.44 |
| แก๊ส NGV | 18.55 | 18.55 | – | – | – | – | – | – | 18.55 |







